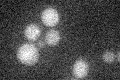
YKL005C
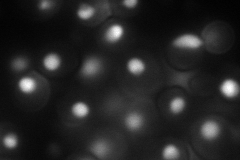
YKL005C
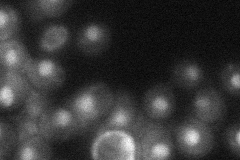
YKL005C
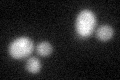
YKL005C

View description
Negative regulator of transcription elongation, contains a TFIIS-like domain and a PHD finger, multicopy suppressor of temperature-sensitive ess1 mutations, probably binds RNA polymerase II large subunit
Localization:
Intensity:
Fold change:
Significance:
-
C’ GFP library in SD
below threshold15.54 -
N' NOP1pr-GFP in SD
nucleus98.6997 -
N' TEF2pr-mCherry in SD

nucleus136.784 -
N' NATIVEpr-GFP in SD
nucleus28.2319 -
N' TEF2pr-VC and Cyto-VN in SD

nucleus50.4176 -
C’ GFP library in SD+DTT
cytosol16.41.05No -
C’ GFP library in SD+H2O2

cytosol15.611No -
C’ GFP library in Starvation Media

cytosol16.961.09No -
C’ GFP library on the background of Pup2-DaMP

below threshold -
C’ GFP library on the background of CCT mutant

below threshold17.96731.15594No
